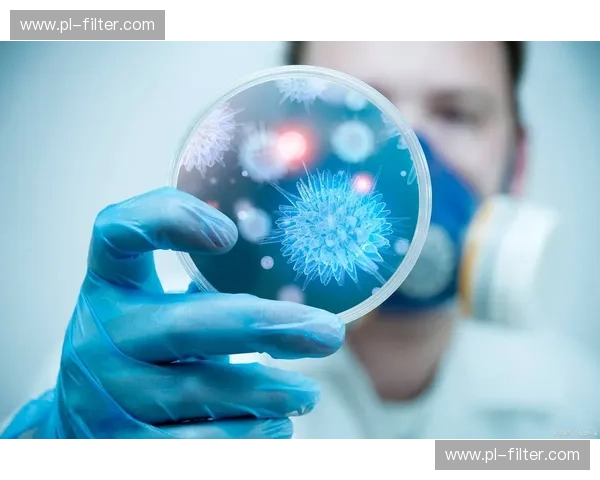
伤病ATP：让康复更科学、更快速、更持久

它把医学支持、训练计划、营养补给和心理疏导四大模块融为一体,让受伤的运动员或普通人都能找到合适的出路。伤病ATP的核心理念是用科学把握恢复节奏,用系统降低复发风险。在评估阶段,专业团队通过体能测试、影像资料与伤史访谈,精准描绘损伤图谱与功能缺口,为下一步的个性化方案奠定基础。
训练模块结合康复与提升,既有针对性恢复练习,也有循序渐进的负荷训练,既保证受伤部位愈合,又促进整体体能重建。营养支持方面,伤病ATP提供个性化的营养配方和恢复加速餐单,针对炎症抑制、肌肉修复与能量恢复三大目标进行优化。心理支持常被忽视,但对恢复进程影响巨大;ATP的心理辅导帮助患者重建自信,缓解焦虑,调整目标与动力。
许多已体验者分享,借助伤病ATP,他们能更快重回赛场,也在日常生活中感到减少痛感与更稳固的身体协调。伤病ATP还搭建了线上社区与复健档案,让康复过程可视化、可追踪,亲友与教练都能参与监督与鼓励。无论你是职业运动员、健身爱好者,还是因意外受伤的普通人,伤病ATP都能在科学、效率与人文关怀之间找到恰当的平衡。
我们相信,康复不仅是时间堆积,更是策略与执行的艺术;伤病ATP就是这门艺术的实践者。现在就加入伤病ATP的体验计划,给自己一条更稳、更快、更安全的康复yl7703永利道路。我们提供一对一评估、专业物理治疗师与运动康复教练联动、营养师定制餐单、心理咨询与数据化追踪,每一步都有明确目标与进度反馈。
试用者常反馈疼痛感明显下降、活动度恢复加速、对运动技能的信心提升,许多人在短期内恢复到受伤前七成至九成的水平。我们的课程灵活,可按周、按月或按疗程购买,还可为团体、俱乐部制定专属方案,帮助团队在赛季中保持最佳状态并降低伤病停赛率。选择伤病ATP,你得到的不只是康复计划,更是一套能与生活、训练无缝衔接的长期健康管理体系,我们陪伴每一步直到你再次自信起跑。
立即扫码或访问官方网站预约免费评估,开启属于你的康复加速之旅。我们承诺透明方案与专业保障,所有数据保密,疗效跟踪公开可查。咨询热线:4008001234(工作时间)伤病ATP,重建你的运动人生,陪你再创高峰。从初诊到完全回归,伤病ATP划分为评估、干预、强化与维持四个阶段,每个阶段都有明确的目标与可量化指标。
评估阶段重点在于找出功能性缺陷,如关节活动受限、肌力不对称或神经传导受阻,并据此生成伤病风险评分。干预阶段由物理治疗师和康复教练联合实施,采用手法、牵伸、电疗等手段解除症状,同时引入低负荷功能性训练保持组织适应性。强化阶段注重恢复力量、速度与协调性,计划中包含权重训练、敏捷练习与专门的技能还原训练,所有动作均量化记录。
维持阶段则把重点放在避免复发与长期表现优化,个性化的维护计划结合定期复诊与数据回顾,帮助你把恢复变成新的常态。真实案例一:李先生,业余足球爱好者,膝前交叉韧带轻度撕裂,经过三个月的ATP康复课程,他回归球场且跑动稳定性提升明显。真实案例二:张女士,健身房受伤后肩关节功能下降,经过ATP的手法治疗与功能训练后,她的举重动作恢复到此前水平,并能继续挑战更高负荷。
常见问题:一、是否只针对运动员?答案是否定的,任何因运动或日常生活导致的肌肉骨骼伤病都适用。二、需要多长时间见效?因人而异,但大多数人能在四至十二周内看到显著改善。三、价格如何?伤病ATP提供多档方案,单次评估、短期疗程与年卡制任君选择,同时对学生与基层俱乐部有优惠。
我们强调个性化而非模板化,每位用户都能获得专属档案与可视化康复曲线,数据支持下的调整让效果更稳定、回归更持久。我们与多家医院及体育科研机构合作,保证方法论与技术持续更新,治疗团队也定期进修与考核,专业力长期加持。现在参加ATP会员,可享首月折扣、线上答疑与优先预约,俱乐部或团体报名还有定制化折扣及数据共享权限。
如果你正在为伤病烦恼,或者希望降低未来受伤风险,欢迎带着问题来,我们会先倾听,再给出科学可行的方案。联系我们:官网、微信公众号与门店均可预约。加入伤病ATP,给自己一个以科学为后盾的康复伙伴,与疼痛说再见,以更强的姿态迎接每一次挑战。所有个人资料与康复记录严格保密,我们尊重每位客户的隐私与选择。
现在预约,还可获得一次免费运动风险评估与初期训练计划。迈出第一步,让伤病成为过去,让活力成为未来。扫描二维码立刻体验。专业团队将为你量身服务,随时回答你的每一个疑问。现在预约吧







